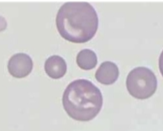
term image
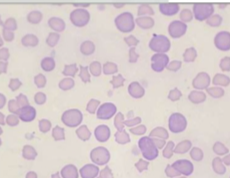
term image
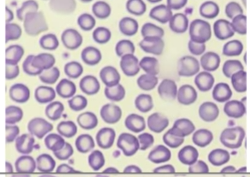
term image
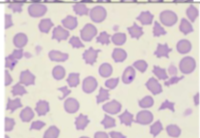
term image
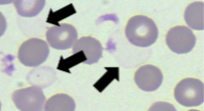
term image
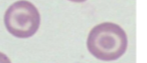
term image
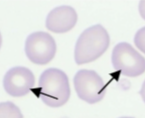
term image
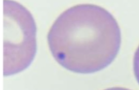
term image
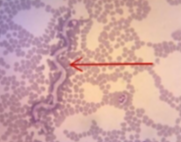
term image
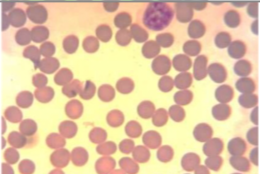
term image
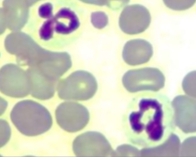
term image
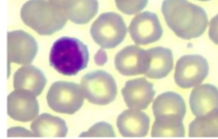
term image
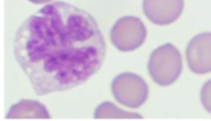
term image
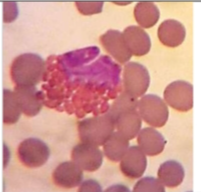
term image

1/71
Looks like no tags are added yet.
Name | Mastery | Learn | Test | Matching | Spaced | Call with Kai |
|---|
No analytics yet
Send a link to your students to track their progress

#1
oculars

#2
interpupillary distance

#3
binocular tube (head)

4
arm

5
objectives

6
coarse focus

7
fine focus

8
condenser height adjuster

9
iris diaphragm lever

10
power cord

11
nosepiece or turret

12
mechanical stage

13
x-y directional knob

14
condenser

15
light source

16
power switch

17
clamping screw

18
dimmer switch

19
hand rest

20
base
pcv range for canine
37-55%
pcv range for feline
30-45%
pcv range for equine
32-53%
TP range for dogs and cats
6.0-7.5 g/dl
TP range for equine
6.0-8.5 g/dl
specific gravity range feline
1.020-1.050
specific gravity range canine & horses
1.020-1.045
Hemoglobin estimate formula and units
PCV/3 g/dL
erythrocyte estimate formula and units
PCV/6 M/microliter
MCV formula and units
PCV*10/RBC fL
what is an increased MCV termed
polycythemia
what is a decreased hemoglobin termed
hypohemoglobinemia
increased MCV is termed
macrocytic
decreased MCV is termed
microcytic
MCHC formula and units
HGB*100/PCV g/dL
decreased mchc is termed
hypochromic
MCH formula and units
HGB*10/RBC pg
anisocytosis
polychromasia
hypochromasia
poikilocytosis

acanthocyte (spur cell)

blister cell

keratocyte

apple stem cell

schistocyte

spherocyte

eccentrocyte

elliptocytes
ghost cell

echinocyte

stomatocyte
codocyte
torocyte

dacrocyte
howell-jolly bodies

heinz bodies

basophilic stippling
microfilaria

RBC Paraasite
babesia spp.

RBC parasite
Anaplasma marginale

RBC parasite
cytauxzoon felis
rouleaux

agglutination
neutrophil
lymphocyte
monocyte
eosinophil

basophil
hematocrit tubes centrifuge settings
10000-15000 RPM for 5 minutes
centrifuge settings for blood tubes
2000-5000 for 10 minutes
centrifuge settings for urine
1500-2000 rpm for 5 minutes